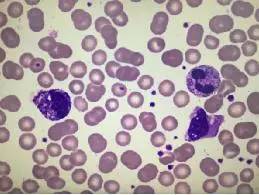

2016-07-13 23:38
作者 高桐

高桐 谢万木 刘颖梅 崔晓敬 陶新曹 曹彬
中日友好医院呼吸与危重症医学科二部
患者男,19岁,大学生,主因“发热伴咳嗽7天”以“肺部感染”于2016年5月收入院。
患者既往体健,7天前外出旅行受凉后出现发热,Tmax39.0℃,伴畏寒、寒战、头晕、咳嗽,无痰,当地抗感染治疗无明显好转。4天前体温升高,Tmax 40℃,多于下午及夜间发热,咳嗽加剧、咳黄色痰,伴腹泻,血常规示WBC 18.63×109/L,NEUT% 83%,CRP 137mg/L,ESR 44mm/h,PCT 14.37ng/ml,结核感染T细胞斑点试验 (T-SPOT)抗原A 100 SFCs/2.5×1, 抗原B 50 SFCs/2.5×1;胸部CT(图1):多肺叶、段斑片状影,结节影,小叶性实变;应用厄他培南+左氧氟沙星抗感染治疗3天,后联合阿奇霉素1天,症状无好转,转入我院。


图1
入院查体未见明显阳性体征,完善检查WBC 19.86×109/L,NEUT 83.8%,CRP 73mg/L,PCT 6.11ng/ml,ESR 41mm/h,血K+ 3.3mmol/L,Na+ 130mmol/L,结核杆菌抗体试验阴性,尿、便常规、肝肾功、血脂、肿瘤标记物均未见明显异常,考虑社区获得性肺炎(Community Acquired Pneumonia,CAP),非典型病原体可能性大(不除外肺结核,暂无结核病原学证据),经验性给予阿莫西林/克拉维酸钾联合盐酸米诺环素抗感染,并积极补液、纠正电解质、镇咳、化痰等对症治疗,继续查痰病原学。
入院第3日,仍高热,仔细查体发现右侧腋窝可触及一2×2cm质硬、活动度可、无压痛淋巴结。患者高热,胸部CT示多发结节影,积极抗生素治疗无效,恶性疾病不除外,外周血涂片示(图2):分叶 52%,单核细胞18%,白细胞明显增多,中性粒细胞可见中毒颗粒,单核细胞增多。次日行骨髓穿刺活检术,病理示(图3):骨髓增生活跃,造血细胞成分约占70%,粒系增生显著,各阶段均可见,早幼粒细胞增多,红系增生,以中晚幼红为主,巨核系不少,形态未见著变。骨髓需氧及厌氧培养均阴性,骨髓血液病免疫分型筛查、IG基因重排检测、MDS相关基因检测等未见血液疾病证据。此时多次血培养、痰涂片染色、痰培养均无病原菌阳性发现,衣原体、支原体、腺病毒核酸阴性,痰Gene-Xpert(-),PPD(+)。支气管镜检查结果显示:右肺下叶支气管粘膜充血、水肿,内基底段管腔可见脓性分泌物,余镜下未见异常;右下叶支气管刷检,刷片细菌涂片、抗酸染色、查霉菌等均阴性;右中、下叶支气管灌洗,BALF细菌及真菌培养均阴性,细胞学检查见大量中性粒细胞。
图 2

图 3
入院第4日,患者体温仍较高,Tmax>40℃,WBC32.56×109/L,NEUT 88%,CRP 127mg/L,PCT 23.7ng/ml,ESR 53mm/h。入院第5日复查胸部CT(图4):右肺中、下叶及左肺可见斑片及结节样实变影,右侧胸腔内见积液影,较前进展。痰结核分支杆菌荧光核酸测定(TB-DNA)回报为阳性,复查痰Gene-Xpert阳性,诊断肺结核。予异烟肼+利福平+吡嗪酰胺+乙胺丁醇及莫西沙星抗结核治疗。


图 4
应用抗痨药物后体温逐渐下降,抗痨治疗第7日复查血常规示WBC10.85×109/L,NEUT 88%,CRP 4mg/L,ESR 15mm/h,PCT 0.09ng/ml,体温未再升高,停用莫西沙星后出院,转诊当地结防所,继续HRSZ四联痨,1月后复查胸部CT(图5)可见斑片影明显吸收,抗结核治疗有效,继续抗痨药物应用


图 5
本例患者急性起病,结合呼吸道症状、胸部浸润影、外周血WBC升高,首先考虑CAP。但是,肺部CT肺内病灶以结节和团块为主,这样的肺部病变常提示肉芽肿性因,并且大学生是肺结核好发人群,但是PCT异常升高干扰了早期诊断。两种痰结核分支杆菌核酸检测阳性给医生信心,联合抗结核治疗取得明显疗效。
PCT 常作为细菌感染脓毒症的鉴别诊断工具,但是,在严重应激状态下,如:大手术、外伤、移植、重症胰腺炎、淋巴瘤等,PCT也可以异常升高。肺结核PCT往往正常或轻度升高(Int J Tuberc Lung Dis 2014;18(4):470–477),但是本例肺部病变短时间进行性加重,PCT升高代表机体的急性应激反应。

以上文章为京港感染论坛独家编辑,转载需要获得许可,并标明来源,投稿热线:pidmic@126.com。


